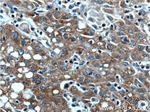
BAX Antibody in Immunohistochemistry (Paraffin) (IHC (P))

Search
Proteintech
BAX Monoclonal Antibody (4G5E8)
{{$productOrderCtrl.translations['antibody.pdp.commerceCard.promotion.promotions']}}
{{$productOrderCtrl.translations['antibody.pdp.commerceCard.promotion.viewpromo']}}
{{$productOrderCtrl.translations['antibody.pdp.commerceCard.promotion.promocode']}}: {{promo.promoCode}} {{promo.promoTitle}} {{promo.promoDescription}}. {{$productOrderCtrl.translations['antibody.pdp.commerceCard.promotion.learnmore']}}
产品信息
60267-1-IG
种属反应
已发表种属
宿主/亚型
分类
类型
克隆号
抗原
偶联物
形式
浓度
规格
纯化类型
保存液
内含物
保存条件
运输条件
产品详细信息
Immunogen sequence: MDGSGEQPR GGGPTSSEQI MKTGALLLQG FIQDRAGRMG GEAPELALDP VPQDASTKKL SECLKRIGDE LDSNMELQRM IAAVDTDSPR EVFFRVAADM FSDGNFNWGR VVALFYFASK LVLKALCTKV PELIRTIMGW TLDFLRERLL GWIQDQGGWD GLLSYFGTPT WQTVTIFVAG VLTASLTIWK KMG (1-192 aa encoded by BC014175)
靶标信息
BAX is a members of the Bcl-2 Family and plays an important role in regulation of apoptosis. Whereas Bcl-2 is commonly regarded as an anti-apoptotic protein, BAX is considered to have a pro-apoptotic function. Regulation of apoptosis is supposed to involve both homo- and heterodimerization of different isoforms of BAX and Bcl-2. The Bax gene encodes different isoforms including Bax alpha (21 kDa) and Bax beta (24 kDa), whereas both isoforms contain the BH1, BH2 and BH3 domains, Bax beta has a unique carboxyl terminus and does not contain a hydrophobic transmembrane domain. Bcl-2 is also expressed in different Isoforms. Bcl-2 beta differs in the 3' UTR and coding region compared to variant alpha. Bcl-2 beta is shorter (22 kDa) and has a distinct C-terminus compared to Bcl-2 alpha (26 kDa). BAX is a member of the BCL-2 family of proteins, which function as regulators of apoptosis. Overexpression of BAX functions to promote cell death. BAX can form homodimers and is also able to heterodimerize with other BCL-2 related proteins.
仅用于科研。不用于诊断过程。未经明确授权不得转售。
生物信息学
蛋白别名: alternatively spliced; Apoptosis regulator BAX; Bax zeta; Baxdelta2(G7); Baxdelta2(G8)-RFS protein; Baxdelta2G9; Baxdelta2G9omega; Baxdelta2omega; Bcl-2-like protein 4; BCL2 associated X protein; BCL2-associated X protein omega; Bcl2-L-4; unnamed protein product
基因别名: BAX; BCL2L4
UniProt ID: (Human) Q07812, (Mouse) Q07813
Entrez Gene ID: (Human) 581, (Rat) 24887, (Mouse) 12028